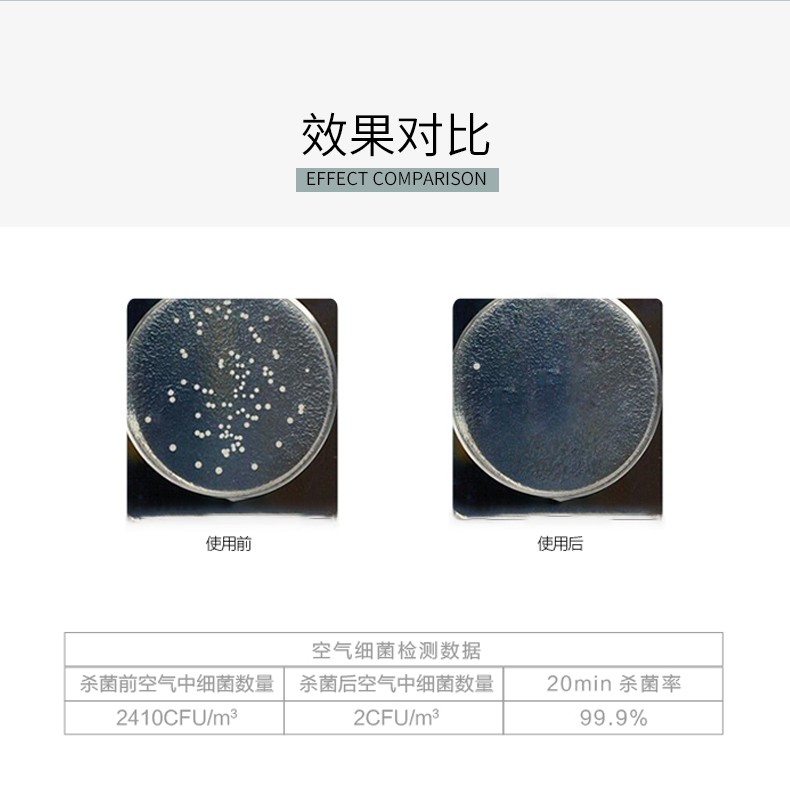
消毒剂 (10).jpg

- 综合评分:
-
1.0000
店铺动态评分 与行业相比
- 商品评分 3.0000 高于 300%
- 服务评分 0.0000 持平 ----
- 物流评分 0.0000 持平 ----
- 店铺名称:
- 浩浩百货专营店
- 信 用 度:
-

- 创店时间:
- 2022-01-05 15:54:36
- 联系电话:
- 15975624081
- 详细地址:
- 广州市天河区渔沙坦渔兴路45号403房

蓝漂本色抽纸16包装(橘子熊猫)LP-26045本色抽纸16包
¥15.00

¥33.00

¥1,000.00

¥450,000.00

¥90,000.00

0 好评
总共0人参加评分
我要评价